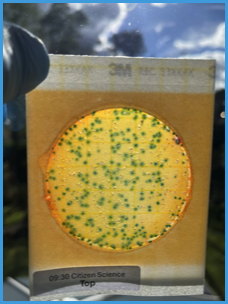

Cleaner Nidd, Fit for Life
Tackling Pollution of our rivers - in Parliament.
1. We are working 'On the Ground' to understand the sources and causes of Nidd pollution
- through collaboration with other key stakeholder organizations such as the Yorkshire Dales Rivers Trust (YDRT), The Environment Agency (EA), Yorkshire Water, environmental organisations, our universities and individual citizens
- We are currently working as part of a Yorkshire-wide AQuA research project with just these aims.
- This follows recent work with YDRT, EA and YW on Oak Beck
3. Another ‘angle’ we are following is to scrutinise plans and strategies in PARLIAMENT

There have been 2 major reports ‘Commissions’ this year.
The Cunliffe Report, commissioned by the UK Government Independent Water Commission Final Report focused on improving the current model of our privatised water sector through better regulation and setting up of new regional planning bodies to balance the competing demands on our river catchments in a more holistic way.
It made 88 recommendations that are being considered by Government.
The Peoples Commission report took a broader view, with independent academics tabling and receiving evidence from experts around the world about what ‘worked’ and listening to the public face to face. Their 6 recommendations were to:
- setup a strategic advisory group of experts
- transition to public ownership of water
- reform governance to include worker and service user directors
- hold those responsible for pollution accountable
- improve democratic oversight and public participation
- establish a single regulator for water.

Office for Environmental Protection Report
This report:
- states that DEFRA, EA and OFWAT have not applied the law, and that ‘exceptional circumstances’ for the dumping of sewage into our rivers means just that - NOT allowing the excuse of inadequate capacity of assets to cope with surface and waste water flow.
- calls for the updating of ‘Permits’ granted by EA to water companies, so that they comply with the law.
Actions from YOU please
- your MP and local councillors to ensure that they are aware of, and active in promoting effective regulation of water in the light of these reports and the impending White Paper on water
- the EA to ask when they will be updating their permits so that they comply with the law. Philip Duffy, CEO of the Environment Agency, Horizon House, Deanery Road, Bristol email them here
It is not enough to gather evidence directly from our river Nidd, important as that is.
We need to inform and influence our politicians and our government into improving the law and the regulatory structure and rules that currently allow and do not check harmful pollution.
Our Aims
A Cleaner Nidd, Fit for Life
Make rivers safe for all.
Stop sewage pollution.
Raise the bar.
Where are we at
- 'The Lido now has designated Bathing Water Status as a result of community pressure, and Environment Agency is undertaking weekly E. Coli samples. To see the latest results Bathing water quality The September 23rd published result, taken at the Lido at the same time as the NAG / AQuA project citizen science samples was 5900 cfus (way above the 1000 cfus POOR water quality limit)
- Yorkshire Water have proposed investment in sewage treatment and the sewerage network in their business plan for 2025-2030 Yorkshire Water have proposed investment in sewage treatment and the sewerage network in their business plan for 2025-2030 Read more here and here.
- A document from January 2024 summarises very briefly what NAG did in 2023, with links to two maps showing the results of our sampling in terms of human health and chemical pollution at the 45 locations sampled. View it here. The document also identifies what we don't yet know and therefore what we need to do to fill in those gaps in our knowledge during 2024 and beyond, building on what we have discovered during our 2023 surveys.
- Results from the NAG and other volunteers' Oak and Bilton Becks Outfall Safari will be announced here very soon, plus an opportunity to question EA and YW about follow up activities
- The AQuA project that NAG is involved in will present its findings soon from the September 16th sampling at the Lido to test the validity of our citizen science methods
- The 2026 sampling activities on the Nidd are being planned, and a call for volunteers for quarterly sampling of identified stretches of the Nidd in Spring will go out soon.
Recent News
5th November
9th October
3rd August
6th July
23rd June
23rd June
14th May
Have a Nice Day and Raise Funds for NAG! Details here
3rd April
24th March 2025
Further information here………
You have got to read this practical stuff from the experts who will be at our meeting. Lots of food for thought, and for action.
Come along and take part. You are welcome anytime, and there is a session particularly for the general public from 2.45 onwards.
Together we can make a difference to the Nidd

The Government has just launched an official commission (web references in the media release below).
independent individuals concerned about the limited scope of this have launched a parallel 'Peoples Commission', reporting in the same short time scale . (more information in all of the web links below)
NAG encourages you to get involved in both commissions, but especially in the Knaresborough event on March 31st! (the agenda is above)
For us, we have an opportunity to take part face to face, as one of the four sessions, on 'Resilient Water Systems' is being held in Knaresborough on March 31st, hosted by Nidd Action Group
Our NAG Public Meeting on February 25th included discussion about more natural ways of handling surface-water and treating waste-water, that avoid or minimise the use of concrete.
Now we have experts in Universities and in engineering (and in Knaresborough)showing us how we might do better! And we can have our say!
peoplescommission_brief_media_release.pdf
commission_knaresborough_agenda.pdf
commission_panel2.pdf
Come along! Any questions before the event, email us here
and to register for any of the four peoples commission events, including our knaresborough event, 'reserve a spot' on
People's Commission: International Water Systems Tickets, Thu 27 Mar 2025 at 13:00 | Eventbrite
13 March 2025
Poster for the March 31st meeting here
Please advertise the meeting to your friends, family, colleagues, groups. We want a large number of committed, informed local citizens at the meeting, so we can improve our rivers for the long term.
7 March 2025
5 March 2025
18th February 2025
View NAG's annual report for 2024, which includes our Aims for 2025 and beyond here
It reminds you what NAG has been up to and outlines the ways in which volunteers can help the River Nidd, learn some skills and enjoy themselves too!
If you have any comments about the report, please send them to us here
Better still, come along to our public meeting in Knaresborough next Tuesday February 25th! Programme here
Talk with us and a variety of experts PLUS those responsible for making and delivering the plans to improve the river over the next five years.
It's your best chance to make an impact!"
2 February 2025
28th January 2025
9th January 2025
8th January 2025
Here is another published report about the SAS / Watershed / University of York surveys of national bathing waters, including NAG's work on the Nidd at the Lido. Click to read the report
8th January 2025
A public meeting is being arranged in late February with all major stakeholders (including YOU!) at which the plans for the river Nidd will be presented and discussed. NAG's Annual General Meeting will also be held during the event, which will be at COGS in Gracious Street, Knaresborough.
More details to follow'.
20th December 2024
16th December 2024
12th December 2024
5th December 2024
27th November 2024
20th November 2024
6th November 2024
16th October 2024
16th October 2024
11th October 2024
11th October 2024
3rd October 2024
The bathing water season has ended for the Nidd at Knaresborough's Lido (though not for Knaresborough's hardy wild swimmers, who keep swimming throughout the year)
That means that Environment Agency weekly monitoring for E. coli concentrations (a marker for risk to human health when swimming) ceases. There is still one more data value to be published. Bathing water profile (data.gov.uk)
The latest available concentration on September 20th is 1700 cfus
Above 900 cfus the water is regarded as POOR for swimming, and requires investigation and improvement
Of the 20 samples taken so far 75% have shown POOR quality, with extreme concentrations of 9300 on July 15th and 5800 on September 10th.
This link provides more details of NAG's activities at the Lido and along the whole of the river Nidd, and the research into the Nidd that NAG is involved with, including some results we are expecting within weeks.
Now we await the Environment Agency and Yorkshire Water's response to this information, and NAG intends to work closely with them and other stakeholders to make rapid and sustainable improvements in water quality
26th September
6th September 2024
22 August 2024
The whopping fine by OFWAT to Yorkshire Water is now a couple of weeks old. NAG has held back its comments to let the dust settle before providing some rational suggestions for what needs to change in order to have improved river water quality.
We have met with our new MP, Tom Gordon, at The Lido, see the attached NAG briefing document we provided for him.
NAG has a meeting arranged in early September with the Head of Yorkshire Water's River Health team
Collaborative activities with the major stakeholders, organised by YDRT and NAG, are being discussed in September.
We are working hard with others to improve the Nidd
22 August 2024
Keith Wilkinson and his colleagues from the Bilton Conservation Group produced this report in 2022 about pollution in Oak Beck, Harrogate over the years.
BCG have worked for decades, and continue to work on getting the beck clean and healthy.
This report was submitted to the leaders of DEFRA, OFWAT, North Yorkshire County Council and Yorkshire Water in an attempt to get some action to improve the river.
The report contains a wealth of relevant information for us all to guide continuing efforts to improve the river.
28th July 2024
22nd July 2024
13th July 2024
9thth July 2024
3rd July 2024
Saturday July 20th from 1.30 onwards at St Peters Church Hall, Addingham, Ilkley
An afternoon (and evening if you want some hands on outdoors stuff) all about the Wharfe. Displays, talks and discussion details attached
The Wharfe, the Nidd's bigger neighbour, was the inspiration for NAG's citizen science work and getting Bathing Water Status.
They are a great bunch of people and we still have a lot to learn from them. I am going! More details here